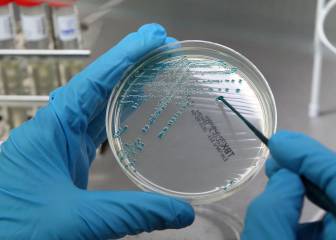
cancer day

Inteligencia artificial para luchar contra el cáncer con bases de pacientes compartidas
Cada año se calcula que se producen 3,7 millones de nuevos casos de cáncer y 1,9 millones de muertes por esta enfermedad se dan en Europa.

Según la Organización Mundial de la Salud, Europa registra un cuarto de todos los casos de cáncer del planeta. Cada año, se calcula que se producen 3,7 millones de nuevos casos de cáncer y 1,9 millones de muertes por esta enfermedad en Europa. Esta enfermedad es la segunda causa principal de muerte en la región, después de las afecciones cardiovasculares.
Hoy en día, los principales proveedores de asistencia sanitaria y diversas organizaciones están utilizando tecnologías como la Inteligencia Artificial (IA) para apoyar a los pacientes, capacitar a los médicos y acelerar la investigación con el objetivo de dar un paso más para controlar y vencer la enfermedad.
Una red social contra el cáncer: #waroncancer
La red social tiene su base en Estocolmo y busca compartir, inspirar y ayudar a pacientes con cáncer. Microsoft
Las redes sociales son hoy el gran nexo de unión de cada colectivo. Madres blogueras, vecinos por barrios que comparten problemas locales, hasta redes para pasar duelos, por ejemplo, tienen cada vez más adeptos. Por eso esta nueva red social puede ayudar a tantos familiares y pacientes con cáncer.
Se llama #waroncancer, habrá 150 bloggers que representan 40 tipos de cáncer. Todos han destacado que la mayoría de los pacientes oncológicos sufren de baja autoestima y depresión.
Con esta premisa, WarOnCancer comenzó a trabajar con seis socios de la industria farmacéutica y biosanitarios para desarrollar y probar una nueva aplicación móvil, cuyo objetivo es convertirse en una red social de alcance mundial para enfermos de cáncer.
La nueva aplicación, cuyo lanzamiento está previsto a lo largo de este año, permitirá a los miembros compartir sus datos y hacer un seguimiento de cómo la industria utiliza esta información para la investigación.
Gracias al poder de Microsoft Azure, WarOnCancer podrá analizar estos datos para detectar deficiencias y beneficios que experimentan los distintos grupos de pacientes en función de dónde y cómo se les trata.
El objetivo a largo plazo de esta red social es crear un servicio de ‘emparejamiento’ para ensayos clínicos y pacientes. "Así, se aumentarán el número de estudios con resultado positivo, encabezarán el proceso de investigación y desarrollo farmacéutico, adaptará los programas de tratamiento y la medicación a las necesidades de los pacientes de cáncer y, en última instancia, salvará vidas”, señaló Sebastian Hermelin, cofundador y director de las industrias colaboradoras de WarOnCancer.
Cáncer de mama e inteligencia artificial
“Es difícil detectar cáncer en las mujeres con tejido mamario denso, dado que las lesiones aparecen en color blanco en los rayos X. Esto las convierte en perfiles de mayor riesgo de desarrollar un cáncer de mama en comparación con las que presentan senos con baja densidad”, apuntó Gisella Gennaro, Física Médica del Instituto Veneciano de Oncología.
“A través de la IA, podemos evaluar automática y objetivamente la densidad mamaria, lo que puede correlacionarse con la reducción del riesgo de cánceres de intervalos y facilitar la detección temprana".
“Sin la IA sería imposible obtener un análisis tan rápido y preciso. Durante los próximos cinco años, planeamos examinar a más de 10.000 mujeres, ver un aumento en las tasas de detección del cáncer, una disminución en los cánceres de intervalo y una reducción significativa en los costes de detección. Es realmente un paso adelante hacia la medicina de precisión”, explicó Francesca Caumo, directora del Departamento de Radiología del Seno del Instituto Veneciano de Oncología.
En España se diagnostican unos 26.000 casos al año, lo que representa casi el 30% de todos los tumores del sexo femenino en nuestro país. En la actualidad es el tumor más frecuente en la población femenina tanto en países desarrollados como en aquellos en vías de desarrollo.
Te recomendamos en Deporte y Vida
- DEPORTE Y SALUD Elvira Sastre a Jon Kortajarena: "Consumir responsablemente aporta calma mental"
- REPSOL ¿A qué hora debes poner el despertador para levantarte de buen humor? Descubre el secreto del sueño
- DEPORTE Y SALUD La lesión de Varane que le impedirá jugar la semifinal contra el Chelsea
- SALUD Y DEPORTE Rope Training: ¿en qué consiste y cuáles son sus beneficios?
- SALUD Espididol: ¿cómo actúa y en qué consisten sus beneficios?
- DEPORTE Y SALUD ¿Qué síntomas puede causar el citomegalovirus que contrajo Álvaro Morata?